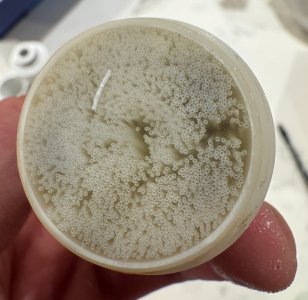
IMG_6926.JPG IMG_6926.JPG

MattS
Well-Known Member
The recommended filter change period is once a year, or sooner if you notice degradation, for Seagulls isn't it? One of my reasons for trying out the Water2 was that the filter specs were the same as Seagulls, including recommended change period, but they cost less.Seagull. Yes, the filter elements are costly, but you don't have to change them every year.